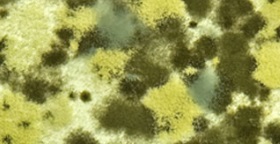

ToxicBlackMould
Information about mould and mould disease
Microbial volatile organic compounds (MVOC)
During growth on water damaged materials many moulds release low molecular weight, volatile organic compounds (MVOCs) as products of secondary metabolism. Several moulds produce volatile metabolites, which are a mixture of compounds that can be common to many species, although some also produce compounds that are genera- or species-specific. Microbial volatile organic compounds are often similar to common industrial chemicals. Scientists have identified more than 200 of these chemical compounds but the list is ever expanding as the research continues.
The presence of many biological agents in the indoor environment is due to dampness and inadequate ventilation. Bacteria and mould living on materials saturated with water bio degrade these substrate materials and in the process release small of volatile chemicals, fungal fragment and spores. Moreover, dampness initiates chemical or biological degradation of materials, which also pollutes indoor air. Dampness has therefore been suggested to be a strong, consistent indicator of risk of asthma and respiratory symptoms (e.g. cough and wheeze). It is believed that mould released volatiles have certain antifungal and cytotoxic properties. Because of this it is possible that under some circumstances microbial volatile organic compounds (MVOC’s) may be partially responsible for complaints ill health and degraded indoor air quality by building occupants.Moulds living on water damaged materials release multitude of volatile compounds. The most common ones are:
Alcohols : 2-methyl-1–propane, 2-methyl-1–butanol, 3-methyl-1–butanol, 2—pentanol, 1-octen-3-ol, 7- octane-2–ol, 3–octanol, 1–decanol, 2- methyl isoborneole, 1-pentanol, Geosmin
Terpenes: pipene, limonene,
Aldehydes:Formaldehyde, acetaldehyde, Propanal, Butanal, Pentanal, Hexanal, Octanal
Ketons: 2-heptanone, 3-octanone, butanone, 2 pentanone, 2-hexanone, cyclohexanone
Furanes: 3- methyl furan, 2-methyl furan
Sulphur compounds: dimethylsulfide
The presence of 3-methyl-1-butanol suggested the possibility of microbial growth in some cellulose-based material. The presence of 1-octen-3-ol and 2-octen-1-ol is indicative of past water damage and consequent fungal growth.
Limited evidence suggests that exposure to low concentrations of VOCs may induce respiratory irritation independent of exposure to allergenic particulate. Volatile organic compounds may also arise through indirect metabolic effects. The common use of urea formaldehyde foam insulation as a cavity wall insulation and subsequent fungal attack and degradation of this material can lead contamination of properties by formaldehyde gas. Mould colonisation of this material results in releasing of urea from the polymer. During this process formaldehyde is evolved as a derivative, contributing to a decline in indoor air quality.
Some moulds and specifically Penicillium digitatum have evolved to release metabolically active gas ethylene. This mould primarily attacks fruits. If stored fruits are attacked by this fungus it releases ethylene gas which accelerated the ripening process of other fruits thus making them more susceptible to mould attack.
Some penicillia are able to produce geosmin, a volatile compound giving fungal or earthy odour to wine. P. expansum and P. carneum are the two most recently identified species of mould capable of producing this compound when growing on grapes.
